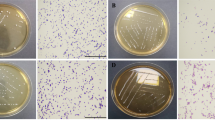

Abstract
The antioxidant activities and probiotic properties of lactic acid bacteria (LAB) selected from traditional artisanal milk cheese from Northeast China were investigated in this study. Among the 322 isolates, 175 LAB were identified through probiotic characterizations. Twenty-three out of the 175 strains exhibited antibacterial activity against more than four enteropathogenic bacteria. The antioxidant action of 23 LAB was evaluated by different methods, including scavenging of hydroxide radicals, DPPH radicals, superoxide anions, and ABTS+ radical cation. The ability to resist hydrogen peroxide and superoxide dismutase activity was also studied. These strains significantly showed antioxidative capacity compared with a non-antioxidative strain, closely followed by the standard probiotic strain Lactobacillus rhamnosus GG or even better. Based on 16S ribosomal RNA-sequence analysis, the 23 isolates belonged to the species Lactobacillus plantarum (16), Lactobacillus paracasei (2), Enterococcus faecium (2), Lactobacillus helveticus (1), Weissella paramesenteroides (1), and Pediococcus pentosaceus (1). In addition, five out of the 23 strains were susceptible to most of the tested antibiotics, showed extremely high levels of hydrophobicity similar to or better than the reference strain L. rhamnosus GG, and did not exhibit any hemolytic activity. These five strains were also confirmed safe through bacterial translocation. Results suggest that at least five probiotic candidates can be explored as prospective antioxidants and used as a potential antioxidant strain to be utilized in the development of functional foods and new starter cultures.
Similar content being viewed by others
Avoid common mistakes on your manuscript.
Introduction
Oxidative stress occurs when abnormally excessive amounts of reactive oxygen species (ROS) [1] and free radicals [2] are generated, resulting in DNA, protein, lipid, and small cellular molecule damage. Moreover, the cellular damage consequently promotes chronic diseases, including cancer, diabetes, and atherosclerosis, as well as cardiovascular diseases, inflammatory conditions, and other degenerative diseases in humans [3]. Antioxidative defense is the first line of defense in the injurious effects of ROS [4]. Other organisms and human bodies possess developed enzymatic and non-enzymatic antioxidative defense and repair systems as protection against oxidative stress. However, under certain situations, these inherent antioxidative systems are generally not sufficient to prevent oxidative damage [5]. Enzyme biosynthesis that can scavenge free radicals is decreasing as age increases. Thus, to reduce oxidative damage, several synthetic antioxidants, such as butylated hydroxytoluene and hydroxyanisole, have been widely used for several decades. However, their safety has recently been questioned due to reports of their liver damage and carcinogenicity [6]. Thus, searching for safe and natural alternative effective antioxidants from bioresources in recent years is significant [7].
The beneficial effects of lactic acid bacteria (LAB) in human health include antimicrobial activity, antiaging, antioxidant activities, enhancing immune potency, and reducing risk of tumors [8]. Generally recognized as safe (GRAS) organisms, LAB are widely consumed with various substrates, fermented foods, and beverages [9]. Most LAB can be safely applied for medical and veterinary functions [10]. Particularly, traditional dairy products, such as yogurt, cheese, vegetables, fermented milk, and meat products, represent several, excellent food sources of probiotics [11]. Some studies reported that some probiotic LAB possess strong antioxidative activity that can decrease the risk of ROS overproduction [12]. LAB can also help the body reduce oxidative damage stress-related diseases from external sources through oral route [13]. Therefore, searching for natural alternative effective antioxidants from the wild LAB in traditional dairy products that might complement or replace current synthetic antioxidants [1] draws great interest.
Among the traditional local artisanal fermented dairy products in the northeast region of China, cheeses were made through natural fermentation without any starter culture. During manufacturing and cheese ripening, the autochthonous microbiota present in milk naturally evolves, growing in the number of LAB species as potential probiotic [14]. Probiotics are one of the most popular cheeses in northeast China. Songisepp and colleagues’ showed that the probiotic Lactobacillus fermentum strain can be used as a novel probiotic, with sustained high antioxidative and antimicrobial activities [15]. Moreover, the LAB strains isolated from traditionally fermented Xinjiang cheese exhibit high potential as starter cultures [16].
Despite that, antioxidative potentials of LAB are generating considerable interest among consumers and researchers, the benefits of this important attribute is yet to be fully explored. Most studies examined some LAB species derived from fermented foods. However, only a few species were used for investigations [17]. No studies are available to date, reporting the antioxidant activities of LAB isolated from traditional Northeast Chinese artisanal cheese. Thus, we explore more new strains of probiotic bacteria to develop antioxidant supplements. In this study, we isolated 322 LAB from four cheese samples obtained from northeast China. Then, we assessed the effects of probiotic properties and antioxidant properties.
Material and Methods
Chemicals, Reagents, and Bacteria
ABTS (2,2′-Azinobis-(3-ethylbenzothiazoline-6-sulfonic acid)) was purchased from Sigma–Aldrich Co. LLC. (USA). The 1,1-diphenyl-2-picrylhydrazyl (DPPH) was purchased from TCI Development Co., Ltd. (Shanghai, China). Tryptone, yeast extract, xylene, hydrogen peroxide, pyrogallol, ascorbic acid, and 1,10-phenanthroline stored from our laboratory and all other reagents and solvents were of research purity grade. Their antioxidative properties and cell-surface hydrophobicity were compared with standard probiotic strain Lactobacillus rhamnosus GG and non-antioxidative strain of Escherichia coli DH5α. L. rhamnosus GG was obtained from Dr. Chunli Ma, College of Food Science, Northeast Agricultural University. E. coli DH5α was purchased from Takara Biotechnology (Dalian, China).
Isolation of Bacteria from Traditional Artisanal Milk Cheese from Northeast China
The artisanal milk cheeses purchased from farmers in the northeast region of China were used in this study. The samples were serially diluted in sterile saline water. A 200 μL of respective dilution was cultured on de Man–Rogosa–Sharpe (MRS) (Hope Bio-technology CO., LTD., Qingdao, China) medium agar plates and incubated at 37 °C for overnight (16–18 h). After cultivation, single, creamy, and opaque colonies were isolated at random and further identified by Gram-staining, morphological, and catalase activities. Colonies with straight rod-shaped Gram-positive, catalase-negative isolates were identified as LAB. Stock cultures were maintained at −80 °C in MRS broth with 50% glycerol. For all subsequent assays, working cultures were transferred at least thrice in MRS at 37 °C overnight (16–18 h). The cultures were obtained and identified by periodic Gram staining to assure their purity.
Acid Tolerance Assay
The ability of the isolates to tolerate low pH was carried out according to Bhakta et al. [18] with some modifications. In short, the MRS broth was adjusted to a pH of 2.0 with HCl solution, and cultures were inoculated in the MRS broth without shaking at 37 °C for 12 h, where in non-treated cultures were used as a negative control. Following acid treatment, the pH tolerance of the cells was determined by calculating the viable bacterial cells on MRS agar plates.
Bile Tolerance of LAB
Resistance to bile salts was assayed following the procedure reported by Bhakta et al. [18]. Briefly, after strains were grown at 37 °C for 12 h in MRS broth, tolerance of bacterial resistance to bile salts was performed in 1 mL MRS broth supplemented with a mixture of bile salts (Huankai Microbial Sci. & Tech. Co., Ltd., Guangdong, China) at different concentrations of 2, 4, and 8 g/L and the blank solution without bile salt. Total viable counts were determined by MRS agar plate assay.
Tolerance of LAB to a Simulated Human Intestinal Juice Tolerance
Intestinal juice tolerance was performed according to the method of Pieniz et al. [19] with some modifications. The 1 mg trypsin (Sigma–Aldrich Co. LLC., USA) with or without 1.5% of bile salts was suspended in 1 mL NaCl solution (0.5%) and adjusted to pH 8.0 to prepare simulated intestinal juice. After 12 h of incubation in MRS medium, our isolates were cell pelleted and washed thrice with 0.1 M with phosphate-buffered saline (PBS, pH 7.2) and resuspended in NaCl solution (0.5%). The 0.2 mL aliquot of cell suspension was mixed with 1.0 mL of simulated intestinal juices and incubated at 37 °C for 12 h. Bacterial growth was measured by MRS agar plates.
Antimicrobial Activity
Antimicrobial activity of LAB isolates was determined by agar well diffusion assay using the non-neutralized and neutralized supernatant [20]. The LAB strains with acid tolerance, bile tolerant, and simulated human intestinal juice tolerance ability were cultured in an MRS broth at 37 °C for 16–18 h. Then, cultures were centrifuged to obtain cell-free culture supernatant (CFCS). The capability of the strains against enteric pathogens was determined using an agar spot test. Three Gram-positive (Staphylococcus aureus CMCC26003, Listeria monocytogenes ATCC19111, and Enterococcus faecalis ATCC29212) and two Gram-negative (Salmonella typhimurium CVCC541 and Pseudomonas aeruginosa ATCC9027) bacteria were used as indicators. All indicator microorganisms were cultured in Luria–Bertani (LB) broth at 37 °C for 16 h under aerobic conditions and then adjusted to 106–107 colony forming units (CFU/mL) and spread (200 μL) on the LB agar plates for 24 h at 37 °C.
One aliquot of 200 μL of CFCS was encased into an Oxford cup, which was set on the surface of the agar. The antimicrobial activity was determined until the formation of clear inhibition zones around the oxford cup (including that of the oxford cup of 7.8 mm) after incubation at 37 °C for 24 h. The same procedure was used to evaluate if the antimicrobial activity of CFCS changed to pH 7.0 using NaHCO3 (5% wt/vol). LAB strains with clear inhibition zones less than 10, 10–16, and 17–22 mm were recorded as negative (−), mild (+), and strong (++) inhibitors, respectively. The experiment was carried out in duplicates. As a positive control, the L. rhamnosus GG growth was estimated. Sterile MRS broth was used as a negative control.
Identification of Selected LAB
16S rRNA analysis was carried out as described by Leite et al. [21]. Total genomic DNA of the isolates was extracted using the TIANamp Bacteria DNA Kit (TIANGEN Biotech, Co., Ltd., Beijing, China), following the manufacturer’s recommendations. Polymerase chain reaction (PCR) was performed using universal primers 27F (5′-AGAGTTTGATCMTGGCTCAG-3′) and 1492R (5′-GGTTACCTTGTTACGACTT-3′) [21]. The PCR products were purified using the quick PCR purification kit (TIANGEN Biotech Co., Ltd., Beijing, China) and were sent to a sequencing company (Comate Bioscience Co., Ltd., Changchun, China). The nucleotide sequences were compared with known sequences in GenBank database using the BLAST program (https://www.ncbi.nlm. nih.gov/BLAST/).
Assay Antioxidant Activity of LAB Strains
Resistance to Hydroxyl Radicals
The hydroxyl-radical-scavenging activity was conducted by the modified method of Ahire et al. [22]. The hydroxyl-radical generation was performed in the solution, which contained 1 mL 1,10-phenanthroline (0.75 mM),1.5 mL sodium phosphate buffer (pH 7.4, 0.15 M), and 1 mL FeSO4 (0.75 mM), 1 mL of H2O2 (0.01%, v/v). In addition, 1.0 mL CFCS was incubated at 37 °C for 30 min. The absorbance at 536 nm was measured. The results were expressed as: hydroxyl-radical-scavenging activity (%) = (Atest − Ablank) / (A′ − Ablank) × 100%, where Atest is the absorbance in the presence of the CFCS, and A′ is the absorbance of both the CFCS and the H2O2 substituted with MRS or ultrapure water. Ablank is the absorbance without the sample and was substituted with MRS or ultrapure water.
Scavenging of DPPH-Free Radical
DPPH scavenging activity of the CFCS was evaluated as described by Ahire et al. [22]. Briefly, 1 mL of 0.2 mM freshly prepared DPPH solution in ethanol was mixed with 0.8 mL CFCS. The mixture was allowed to stand in the dark for 30 min. The blanks contained MRS broth and DPPH solution. The absorbance of the mixture was then recorded at 517 nm. The radical-scavenging activity of CFCS was calculated by the following equation: DPPH radical-scavenging activity (%) = (Ablank − Atest / Ablank) × 100.
ABTS Radical-Scavenging Activity
ABTS radical-scavenging was assayed by a method described by Jia et al. [23] with minor modifications. ABTS+ radical cation stock solution was prepared, and the mixture was kept for 16 h in the dark at room temperature. The ABTS+ solution was diluted by methanol at an absorbance of 0.700 ± 0.020 at 734 nm. CFCS of 100 μL (or standards) was mixed with 3.0 mL ABTS+ solution. Then, the absorbance at 734 nm was measured. The absorbance of the blank solution contains similar proportion (100 μL) of culture medium or ultrapure water. The percentage of inhibition was calculated as follows: ABTS+ radical cation scavenging rate = (1 − Atest / Ablank) × 100.
Resistance to Superoxide Anions
The superoxide anion radical-scavenging assay was tested using the method described by Gao et al. [24] with some modifications. The reaction mixture contains 0.8 mL CFCS and 0.2 mL Tris–HCl buffer (0.1 M, pH 8.0), and the absorbance was measured at 320 nm. After adding 0.1 mL pyrogallol solution (3 mM), A320 was measured. Scavenging ability is calculated as follows: scavenging ability (%) = [1 − (Atest1 − Atest2) / Ablank] × 100, where Atest1 is the absorbance in the presence of the CFCS containing pyrogallol; Atest2 is the sample without pyrogallol; and Ablank is the absorbance without the sample and the blank solution containing pyrogallol.
Superoxide Dismutase Activity
The superoxide dismutase (SOD) activity was measured with commercially available reagent kit (Nanjing Jiancheng Bioengineering Institute, Nanjing, China) according to the manufacturer’s instructions. CFCS was prepared as described previously, and SOD activity was analyzed. SOD activity was expressed as U/mL protein.
Resistance to Hydrogen Peroxide
The reaction to resistance to hydrogen peroxide was performed according to the methodology of Li et al. [17]. Test strains were grown in MRS broth overnight (16–18 h) at 37 °C. The overnight cultures were incubated at 1% (v/v) into MRS broth including 0.4, 0.7, or 1.0 mM hydrogen peroxide at 37 °C for 8 h. The cell growth was estimated by using a microplate reader (BioTek Instruments, Inc., Winooski, VT, USA) at 600 nm.
Cell Surface Hydrophobicity
The cell surface hydrophobicity (H%) assay was performed as per the protocol described by Solieri et al. [25]. Briefly, isolates were cultured in MRS broth for 18 h at 37 °C. The cells were suspended in PBS buffer (pH 7.0) to approximately 109 CFU/mL. Equal volumes of cell suspension (A0) and xylene were added by vigorously vortexing for 2 min and incubated at 37 °C for 10 min. The two-phase system was again briefly vortexed and incubated at 37 °C for 5 h to allow phase separation. The aqueous phase was gently moved, and the absorbance was measured at 600 nm (A1). The percentage of surface hydrophobicity (H%) was calculated as [1 − (A1 / A0)] × 100. All the results were compared with standard probiotic strain L. rhamnosus GG.
Antibiotic Susceptibility
Antibiotic susceptibility of the selected strains was assayed by using disc diffusion method according to previous study [26]. Two hundred microliters (107 CFU/mL) of overnight-grown culture was spread to the MRS plates. The 18 antimicrobial agents were used. The commercial antibiotic discs (KONT Biology & Technology., LTD., Wenzhou, China) (ampicillin, penicillin cephalothin, cefuroxime, cefotaxime, ceftazidime, cefepime, imipenem, cefoxitin, tetracycline, azithromycin, doxycycline, erythromycin, vancomycin, trimethoprim-sulfamethoxazole, clindamycin, chloramphenicol, linezolid) were placed on the seeded agar medium. After incubation under anaerobic condition for 48 h at 37 °C, the plates were observed for the diameter (mm) of clear zone around the disc. The resistance and sensitivity were expressed according to the guidelines of the Clinical and Laboratory Standards Institute (CLSI 2013).
Hemolytic Activity
Blood hemolysis was analyzed on blood agar containing 5% sheep blood agar (Biocell BioTech., Co., Zhengzhou, China) incubated at 37 °C for 24 h. The blood plates were confirmed for β-hemolysis (clear zones around colonies), α-hemolysis (greenish zones around colonies), or γ-hemolysis (no zones around the colonies) [27].
Safety Evaluation in Mice
The safety of the selected five strains in mice was evaluated according to the method of Cui et al. [28]. All animal experiments were approved by the international recommendations for animal welfare and the ethical committee for animal sciences of Heilongjiang Province, China.
Results and Discussion
In this context, we selectively isolated 322 LAB from four traditional artisanal cheese samples. This study aimed to evaluate the probiotic properties of these strains and to screen these strains for acid and bile salt resistance and tolerance to a simulated human gastrointestinal (GI) tract. In addition, we studied the antioxidant properties of the 23 selected strains and compared their features with those of the standard probiotic strain L. rhamnosus GG and the non-antioxidative strain E. coli DH5α. Antimicrobial ability, cell surface hydrophobicity, and antibiotic susceptibility were considered fundamental properties for probiotics.
Acid, Bile, and Simulated Intestinal Juice Resistance
To select probiotic organism, the resistance to pH and bile salts is an essential prerequisite in bacterial survival and growth in the harsh conditions of the stomach [29]. The LAB isolates from cheeses were screened for their resistance and survival in physiological pH environment, physiological bile salt environment, as well as for their growth in simulated intestinal juice at similar concentration present in the proximal intestine [30].
According to a previous study [31], the ability to grow at pH 2.5 ± 0.3 is considered as potential acid tolerance to selected probiotic strains. In the present study, 304 out of 322 LAB isolates grew well with a survival rate of more than 80% in MRS broth after incubation at pH 2.0 for 12 h (Table 1). These values were higher than those reported by Lee et al. [32].
In the human gastrointestinal tract, the relevant physiological concentrations of bile salts are generally 0.3–0.5% [33]. The presence of the acid tolerance strains in different concentration levels of bile salts was also analyzed (Table 1). The 278 isolates maintained 96 and 91% survival rates at concentration levels of 2 and 4 g/L, respectively, for 12 h. In addition, the tested 218 isolates exhibited survival and growth rates of more than 75% at a bile salt concentration of 8 g/L, indicating that these strains can exert resistance even at high bile concentrations. Increased concentration with bile salts indicates decreased survival rates of the isolates. However, 198 of these isolates showed an over 90% survival rate with negative control. Moreover, the strains exhibited resistance to low pH and bile salts. This finding was consistent with the previously reported data [34].
Small intestine tolerance is potentially more significant than gastric survival. Table 1 shows the ability of 198 strains to survive in simulated intestinal juice. The 175 strains showed that similar survival viable cell counts were observed in simulated juices and control. Those strains can tolerate the simulated intestinal juice. In addition, these strains retained good growth when exposed to simulated small intestinal juice for 8 h, indicating that our strains can pass through the intestinal tract.
Our results showed good tolerance to acidic, bile salt, and simulated human intestinal juice conditions (Table 1). Under our experiment conditions, 94 LAB strains were selected and investigated for antimicrobial activity testing.
Antimicrobial Activity
Inhibition of pathogenic bacterial growth in the intestinal tract is one desirable property of probiotic strains in avoiding gastrointestinal infection [35]. Non-neutralized and neutralized supernatants of the 23 strains were utilized to study their antibacterial activity against most of the common enteropathogenic bacteria (Table 2). Strains 27051, 27103, 27186, 27195, 27197, and 27201 showed good antibacterial activity against three Gram-positive (S. aureus, L. monocytogenes, and E. faecalis) and two Gram-negative (S. typhimurium and P. aeruginosa) bacteria. Strain 27051 was more effective against L. monocytogenes than the other strains; whereas the neutralized supernatant displayed comparable activities against S. aureus, L. monocytogenes, S. typhimurium, and P. aeruginosa. However, the inhibition zones of all strains were reduced (Table 2), except for those of strains 27039, 27051, and 27197 that had completely disappeared. Our results indicated that the inhibitory effects of these LAB strains were caused by the production of organic acids [36]. Isolates 27116 and 27322 exhibited inhibitory activity toward all but P. aeruginosa. Strain 27125 exhibited antimicrobial activities against S. aureus, L. monocytogenes, P. aeruginosa, and S. typhimurium. The strain 27110 inhibited the growth of different indicator microorganisms, namely, S. aureus, S. typhimurium, P. aeruginosa, and E. faecalis. The strain 27173 showed are remarkable antagonistic activity against S. aureus, L. monocytogenes, P. aeruginosa, and E. faecalis. Many LAB strains displayed antimicrobial activities at different extents and, thus, exhibited potential application in food preservation. In our study, the results may show that the selected LAB can produce antibacterial active substances. Therefore, the antibacterial activity of LAB strains could be correlated with the finding of Ahire et al. [22] who found similar antimicrobial activity against S. aureus. Several studies have reported the resistance of S. aureus to numerous antibiotics.
Identification by 16S rRNA Sequencing
Sequence comparisons exhibited a homology higher than 99% to six different LAB species. Therefore, the 23 isolates with good antimicrobial activity were identified as follows: Lactobacillus plantarum (16), Enterococcus faecium (2), Lactobacillus paracasei (2), Lactobacillus helveticus (1), Weissella paramesenteroides (1), and Pediococcus pentosaceus (1). The 16S rRNA sequences of our LAB strains were deposited in the GenBank sequence database under accession numbers KX832350–KX832372 (Table 3).
Antioxidant Activity
LAB antioxidant activities are one of the most important probiotic functions [37] and helpful in food and feed industry and affect positively the human health. Given the complex reactive facets of antioxidant, the LAB antioxidant activities cannot be evaluated only by a single method. Various test systems should be used in determining the antioxidant activity to establish authenticity. In this study, the antioxidant effects of our strains were observed by different methods, including scavenging of hydroxide radicals, DPPH radicals, superoxide anions, and ABTS+ radical cation. The ability to resist hydrogen peroxide and SOD activity was also studied based on their above mentioned significant selection criteria. We also tested the antioxidant potential of 23 potential bacteria.
Hydroxyl Radical-Scavenging Assay
Hydroxyl radicals are the most harmful ROS responsible for lipid peroxidation, DNA damages, and oxidative injury of biomolecules [38]. In the presence of the hydroxyl radicals, the CFCS of all the LAB strains included in the study are shown in Table 4. Among the 23 strains tested, L. plantarum 27319 showed the highest hydroxyl-radical-scavenging ability, and its inhibitory capacity reached 416.67%. The scavenging effects of L. helveticus 27051; W. confusa 27116; L. paracasei 27154; E. faecium 27321; L. plantarum 27103, 27110, 27125, 27150, 27156, 27160, and 27320; and Ped. pentosaceus 27322 also scavenged hydroxyl radical well. The hydroxyl-radical-scavenging capacity of these isolates is more than 0.025% ascorbic acid equivalent/mL. Moreover, these strains showed higher scavenging ability than standard probiotic strain L. rhamnosus GG (30.5%). Our results agreed well with those of Wang et al. [39], who also found high scavenging activity of their L. fermentum toward hydroxyl radicals. The percent hydroxyl radical scavenging activity was comparable with that of probiotic L. helveticus CD6 [22]. Evidently, the high scavenging ability of hydroxyl radicals of these strains is one of the potent mechanisms for their increased resistance to ROS.
DPPH Radical-Scavenging Activity
The DPPH radicals were extensively used to evaluate antioxidant activity [40]. Excellent antioxidant activity can be measured via a high percentage DPPH radical scavenging. The DPPH-free-radical-scavenging activity of the CFCS isolate is shown in Table 4. The strain 27319 displayed the highest radical-scavenging activity (39.3%), followed by 27156, 27195, 27197, 27321, and 27322. The free-radical-scavenging activities of these strains were greater than those of the standard probiotic strain L. rhamnosus GG (28.24%), indicating that the substances on the cell surface affect the scavenging activity. The tested strains exhibited high scavenging activities of DPPH and hydroxyl radicals. This result was consistent with those obtained by Gao et al. [24].
ABTS Radical-Scavenging Activity
The results of our LAB were lower than that of the positive control (ascorbic acid). Eight LAB exhibited the higher ABTS radical-scavenging activities than the standard probiotic strain L. rhamnosus GG, namely, 27039, 27051, 27116, 27125, 27134, 27150, 27195, and 27197. Table 4 shows that the high ability to scavenge the ABTS+ radical cation was all greater than those of Han et al. [41]. Other results showed that the scavenging radical activity of L. plantarum C88 decreased because the substances on the cell surface were removed [17].
Resistance to Superoxide Anions
Superoxide anions are the other linchpin ROS. Superoxide anions can also cause injuries to biological molecules through oxidative stress [42]. Thus, we also assessed the resistance of our potential probiotic LAB strains to superoxide anions. The scavenging ability was confirmed as shown in Table 4. Fourteen strains exhibited a scavenging effect upon the superoxide anion radical over the standard probiotic strain L. rhamnosus GG (76%). Furthermore, 27100 and 27103 showed the highest scavenging activity (Table 4), indicating that these 14 strains exhibit high resistance to superoxide anions. One of the possible mechanisms of our test strains is their inhibition of lipid peroxidation in vitro due to the superoxide anion scavenging ability [43].
Superoxide Dismutase (SOD) Activity
SOD is an important enzymatic antioxidant defense mechanism in catalyzing the dismutation of the superoxide anion into O2− and hydrogen peroxide [44]. Sanders et al. [45] showed the presence of such major enzyme in Lactococcus sp. for scavenging ROS. The data on SOD activity of the test LAB strains under investigation as recorded in Table 4 demonstrates that the SOD level ranged from 0.53 to 8.62 U. The 27103 and 27125 showed the highest superoxide dismutase content (8.62 U), closely followed by 27160 and 27173 (8.1 U). Our results demonstrated that some of our test isolates, namely, 27103, 27125, 27160, 27173, 27100, 27110, 27134, 27150, 27156, 27195, and 27197 expressed relatively similar or even higher SOD activity than that recorded with standard probiotic strains L. rhamnosus GG (5.65 U). Our data indicate their versatility as possible biotherapeutics in the administration of oxidative stress-induced diseases. Nearly, all the cells and cellular organisms utilize SOD to eliminate superoxide [46]. In this study, we verified a correlation between the SOD activities and the metabolites of LAB [47].
Resistance to Hydrogen Peroxide
Compared with hydroxyl radical, hydrogen peroxide is a feeble oxidant but may lead to hydroxyl radical that causes hydroxyl radical-mediated-oxidative DNA damage. We tested the effect of hydrogen peroxide in the presence of the LAB cells as shown in Table 5. For resistance to hydrogen peroxide, the growth pattern of test strains was compared with the control. The eight strains (27039, 27154, 27186, 27051, 27100, 27156, 27173, 27322) compared with the non-antioxidative strain E. coli DH5α survived longer toward H2O2 at 0.4 mM concentration for 8 h. At 0.4 mM hydrogen peroxide, 12 strains exhibited a moderate resistance for 8 h despite variations in the degree of test culture survival. The L. plantarum 27116, 27125, 27134, 27197, 27201, 27319, 27320, and 27321 remained viable for 0.7 mM hydrogen peroxide (Table 5), closely followed by the reference strains L. rhamnosus GG. The L. plantarum 27150, 27160, and 27177 were the most resistant strains as can be reflected from the optical density, which is better than the standard strain L. rhamnosus GG. This phenomenon demonstrated that increased concentration of hydrogen peroxide means decreased survival rate. Our results with regard to hydrogen peroxide resistance of LAB isolates are constant with those of Lee et al. [48]. L. casei KCTC3260 can remain viable after 7 h of incubation at 0.4 mM hydrogen peroxide [48]. This finding was more than that of L. rhamnosus GG.
Cell Surface Hydrophobicity
The cell surface hydrophobicity of microorganisms is an important selection standard for the first contact of host cells [49]. Cell adherence evaluated by the partitioning ratio of the candidates among aqueous and aromatic (xylene) layers was calculated in a two-phase system. We found that the H% values with the most tested isolates showed hydrophobicity ranging from 50 and 79% (Table 1). The standard probiotic strain L. rhamnosus GG exhibits a good hydrophobic cell surface (66.27%). The calculated hydrophobicity value of L. plantarum 27160, 27186, 27197, L. helveticus 27051, E. faecium 27177, and Ped. pentosaceus 27322 showed the highest levels similar to or even better than that of the recognized probiotic strain L. rhamnosus GG. This work revealed that those strains may be well correlated to the attachment of bacteria to host cell. These findings agreed well with previously reported results [25], thereby, indicating that these strains possessed an adhesive property to epithelial cells.
Safety Properties
Increasing attention has been recently concerned on the links between antimicrobial utilization in farm animal feeding and humans [50]. To evaluate safety aspects, the 23 promising probiotic strains with good antioxidant activities were therefore tested for antibiotic susceptibility and for hemolytic activity.
Table 6 shows the antibiotic susceptibility patterns of the strains. All the 23 isolates were assayed for their antibiotic susceptibility patterns to 18 antibiotics. The tested strains were sensitive to ampicillin, linezolid, imipenem, chloramphenicol or in medium sensitive to ampicillin (except L. plantarum 27110, 27150, 27197, 27319, 27320; and W. confusa 27116), linezolid (except L. plantarum 27110, 27150, 27197, 27319, and 27320), imipenem (except L. plantarum 27110, 27150, 27197, 27319, 27320; W. confusa 27116, 27177, and 27321), and chloramphenicol (except L. plantarum 27110, 27150, 27197, and 27320). Thus, isolates L. paracasei 27039, 27154; L. helveticus 27051; L. plantarum 27100, 27103, 27114, 27125, 27134, 27156, 27160, 27173, 27195; and E. faecium 27177 were selected for further investigation. All tested strains were known to be naturally resistant to vancomycin, which is not transmissible because it is chromosomally encoded. Vancomycin resistance in some Lactobacillus strains is reportedly not a safety concern [51]. Most of the strains, given that the L. rhamnosus GG strain were susceptible to tetracycline and chloramphenicol [27], demonstrate the generally low resistance of the Lactobacilli species to these antibiotics.
The judgment of hemolytic activity is considered a safety property in selecting promising probiotic strains (FAO/WHO, 2002). In this study, none of the examined strains exhibited α-hemolysis and β-hemolysis activities when grown in 5% sheep blood agar. None of our strains also showed that hemolytic activity is always considered as a safety bioresource, ensuring a potential probiotic strain [52]. As shown in Table 7, the incidences of translocation to the lymph node, spleen, and liver of the mice treated with our selected isolates were similar to or lower than that of the standard probiotic strain L. rhamnosus GG. Our results indicated that the incidence of bacterial translocation was not significantly different among the groups of selected probiotic strains and those fed with L. rhamnosus GG. Five strains of L. plantarum 27125, 27150, 27156, 27160 and L. helveticus 27051 were further selected based on the comprehensive selection procedures.
Conclusion
This study showed that five new LAB strains isolated from traditional Northeast Chinese artisanal cheeses showed good probiotic potential and antioxidant activity even better than that of the control strain L. rhamnosus GG. Our results also indicated that the antioxidative work of the putative probiotic LAB varied considerably among species and strains. In our study, we can verify that the antioxidant activities of LAB cannot be evaluated by only a single method, but various test systems should be used for the determination of antioxidant activity to establish authenticity. Moreover, the potential probiotic strains were isolated from food grade samples. Thus, these strains can be safely used in food, people, and other animals. Our selected strains can be combined for probiotic preparation that might also contribute in preventing and controlling oxidative stress-related diseases. These five strains were the desirable health-promoting bacteria with important antimicrobial activity and antibiotic susceptibility combined with prominent antioxidant activity. These results suggest that these five probiotic candidates can be explored as prospective antioxidants and be used as a potential antioxidant strain to be utilized in the development of functional foods and new starter cultures.
References
Kullisaar T, Zilmer M, Mikelsaar M, Vihalemm T, Annuk H, Kairane C, Kilk A (2002) Two antioxidative lactobacilli strains as promising probiotics. Int J Food Microbiol 72(3):215–224. https://doi.org/10.1016/S0168-1605(01)00674-2
Marx JL (1987) Oxygen free radicals linked to many diseases; the oxygen free radicals, although made as by-products of normal oxygen-using reactions, nevertheless have a wide potential for causing cell injury. Science 235:529–532
Nagmoti DM, Khatri DK, Juvekar PR, Juvekar AR (2012) Antioxidant activity free radical-scavenging potential of Pithecellobium dulce Benth seed extracts. Free Radic Antioxid 2(2):37–43. https://doi.org/10.5530/ax.2012.2.2.7
Lobo V, Patil A, Phatak A, Chandra N (2010) Free radicals, antioxidants and functional foods: impact on human health. Pharmacogn Rev 4(8):118–126. https://doi.org/10.4103/0973-7847.70902
Simic MG (1988) Mechanisms of inhibition of free-radical processes in mutagenesis and carcinogenesis. Mutat Res 202(2):377–386. https://doi.org/10.1016/0027-5107(88)90199-6
Luo D, Fang B (2008) Structural identification of ginseng polysaccharides and testing of their antioxidant activities. Carbohydr Polym 72(3):376–381. https://doi.org/10.1016/j.carbpol.2007.09.006
Czerwińska M, Kiss AK, Naruszewicz M (2012) A comparison of antioxidant activities of oleuropein and its dialdehydic derivative from olive oil, oleacein. Food Chem 131(3):940–947. https://doi.org/10.1016/j.foodchem.2011.09.082
Ayeni FA, Sánchez B, Adeniyi BA, Clara G, Margolles A, Ruas-Madiedo P (2011) Evaluation of the functional potential of Weissella and Lactobacillus isolates obtained from Nigerian traditional fermented foods and cow’s intestine. Int J Food Microbiol 147(2):97–104. https://doi.org/10.1016/j.ijfoodmicro.2011.03.014
Leroy F, De Vuyst L (2004) Lactic acid bacteria as functional starter cultures for the food fermentation industry. Trends Food Sci Technol 15(2):67–78. https://doi.org/10.1016/j.tifs.2003.09.004
Holzapfel WH, Schillinger U (2002) Introduction to pre-and probiotics. Food Res Int 35(2–3):109–116. https://doi.org/10.1016/S0963-9969(01)00171-5
Hashemi SMB, Shahidi F, Mortazavi SA, Milani E, Eshaghi Z (2014) Potentially probiotic Lactobacillus strains from traditional Kurdish cheese. Probiotics Antimicrob Proteins 6(1):22–31. https://doi.org/10.1007/s12602-014-9155-5
Kaizu H, Sasaki M, Nakajima H, Suzuki Y (1993) Effect of antioxidative lactic acid bacteria on rats fed a diet deficient in vitamin E. J Dairy Sci 76(9):2493–2499. https://doi.org/10.3168/jds.S0022-0302(93)77584-0
Kullisaar T, Songisepp E, Mikelsaar M, Zilmer K, Vihalemm T, Zilmer M (2003) Antioxidative probiotic fermented goats’ milk decreases oxidative stress-mediated atherogenicity in human subjects. Br J Nutr 90(2):449–456. https://doi.org/10.1079/BJN2003896
Nielsen B, Gürakan GC, Ünlü G (2014) Kefir: a multifaceted fermented dairy product. Probiotics Antimicrob Proteins 6(3–4):123–135. https://doi.org/10.1007/s12602-014-9168-0
Songisepp E, Kullisaar T, Hütt P, Elias P, Brilene T, Zilmer M, Mikelsaar M (2004) A new probiotic cheese with antioxidative and antimicrobial activity. J Dairy Sci 87(7):2017–2023. https://doi.org/10.3168/jds.S0022-0302(04)70019-3
Azat R, Liu Y, Li W, Kayir A, Lin D-b, Zhou W-W, Zheng X-d (2016) Probiotic properties of lactic acid bacteria isolated from traditionally fermented Xinjiang cheese. J Zhejiang Univ Sci B 17(8):597–609. https://doi.org/10.1631/jzus.B1500250
Li S, Zhao Y, Zhang L, Zhang X, Huang L, Li D, Niu C, Yang Z, Wang Q (2012) Antioxidant activity of Lactobacillus plantarum trains isolated from traditional Chinese fermented foods. Food Chem 135(3):1914–1919. https://doi.org/10.1016/j.foodchem.2012.06.048
Bhakta JN, Ohnishi K, Munekage Y, Iwasaki K, Wei MQ (2012) Characterization of lactic acid bacteria-based probiotics as potential heavy metal sorbents. J Appl Microbiol 112(6):1193–1206. https://doi.org/10.1111/j.1365-2672.2012.05284.x
Pieniz S, Andreazza R, Anghinoni T, Camargo F, Brandelli A (2014) Probiotic potential, antimicrobial and antioxidant activities of Enterococcus durans strain LAB18s. Food Control 37(1):251–256. https://doi.org/10.1016/j.foodcont.2013.09.055
Agaliya PJ, Jeevaratnam K (2013) Molecular characterization of Lactobacilli isolated from fermented idli batter. Braz J Microbiol 44(4):1199–1206. https://doi.org/10.1590/S1517-83822013000400025
Leite AM, Miguel MA, Peixoto RS, Ruas-Madiedo P, Paschoalin VM, Mayo B, Delgado S (2015) Probiotic potential of selected lactic acid bacteria strains isolated from Brazilian kefir grains. J Dairy Sci 98(6):3622–3632. https://doi.org/10.3168/jds.2014-9265
Ahire JJ, Mokashe NU, Patil HJ, Chaudhari BL (2013) Antioxidative potential of folate producing probiotic Lactobacillus helveticus CD6. J Food Sci Technol 50(1):26–34. https://doi.org/10.1007/s13197-011-0244-0
Jia N, Xiong YL, Kong B, Liu Q, Xia X (2012) Radical scavenging activity of black currant (Ribes nigrum L.) extract and its inhibitory effect on gastric cancer cell proliferation via induction of apoptosis. J Funct Foods 4(1):382–390. https://doi.org/10.1016/j.jff.2012.01.009
Gao D, Gao Z, Zhu G (2013) Antioxidant effects of Lactobacillus plantarum via activation of transcription factor Nrf2. Food Funct 4(6):982–989. https://doi.org/10.1039/C3FO30316K
Solieri L, Bianchi A, Mottolese G, Lemmetti F, Giudici P (2014) Tailoring the probiotic potential of non-starter Lactobacillus strains from ripened Parmigiano Reggiano cheese by in vitro screening and principal component analysis. Food Microbiol 38(4):240–249. https://doi.org/10.1016/j.fm.2013.10.003
Bauer AW, Kirby WM, Sherris JC, Turck M (1966) Antibiotic susceptibility testing by a standardized single disk method. Tech Bull Regist Med Technol 36(3):49–52. https://doi.org/10.1093/ajcp/45.4_ts.493
Maragkoudakis PA, Zoumpopoulou G, Miaris C, Kalantzopoulos G, Pot B, Tsakalidou E (2006) Probiotic potential of Lactobacillus strains isolated from dairy products. Int Dairy J 16(3):189–199. https://doi.org/10.1016/j.idairyj.2005.02.009
Cui X, Shi Y, Gu S, Yan X, Chen H, Ge J (2017) Antibacterial and antibiofilm activity of lactic acid bacteria isolated from traditional artisanal milk cheese from Northeast China against enteropathogenic bacteria. Probiotics Antimicrob Proteins 1:1–10. https://doi.org/10.1007/s12602-017-9364-9
Charteris WP, Kelly PM, Morelli L, Collins JK (1998) Development and application of an in vitro methodology to determine the transit tolerance of potentially probiotic Lactobacillus and Bifidobacterium species in the upper human gastrointestinal tract. J Appl Microbiol 84(5):759–768. https://doi.org/10.1046/j.1365-2672.1998.00407.x
Xanthopoulos V, Litopoulou-Tzanetaki E, Tzanetakis N (2000) Characterization of Lactobacillus isolates from infant faeces as dietary adjuncts. Food Microbiol 17(2):205–215. https://doi.org/10.1006/fmic.1999.0300
Usman, Hosono A (1999) Bile tolerance, taurocholate deconjugation, and binding of cholesterol by Lactobacillus gasseri strains. J Dairy Sci 82(2):243–248. https://doi.org/10.3168/jds.S0022-0302(99)75229-X
Lee NK, Yun CW, Kim SW, Chang HI, Kang CW, Paik HD (2008) Screening of Lactobacilli derived from chicken feces and partial characterization of Lactobacillus acidophilus A12 as an animal probiotics. J Microbiol Biotechnol 18(2):338–342
Dunne C, O'Mahony L, Murphy L, Thornton G, Morrissey D, O'Halloran S, Feeney M, Flynn S, Fitzgerald G, Daly C (2001) In vitro selection criteria for probiotic bacteria of human origin: correlation with in vivo findings. Am J Clin Nutr 73(2 Suppl):386S–392s. https://doi.org/10.1093/ajcn/73.2.386s
Turchi B, Mancini S, Fratini F, Pedonese F, Nuvoloni R, Bertelloni F, Ebani VV, Cerri D (2013) Preliminary evaluation of probiotic potential of Lactobacillus plantarum strains isolated from Italian food products. World J Microbiol Biotechnol 29(10):1913–1922. https://doi.org/10.1007/s11274-013-1356-7
Kanmani P, Satish KR, Yuvaraj N, Paari KA, Pattukumar V, Arul V (2013) Probiotics and its functionally valuable products—a review. Crit Rev Food Sci Nutr 53(6):641–658. https://doi.org/10.1080/10408398.2011.553752
González L, Sandoval H, Sacristán N, Castro JM, Fresno JM, Tornadijo ME (2007) Identification of lactic acid bacteria isolated from Genestoso cheese throughout ripening and study of their antimicrobial activity. Food Control 18(6):716–722. https://doi.org/10.1016/j.foodcont.2006.03.008
Dilna SV, Surya H, Aswathy RG, Varsha KK, Sakthikumar DN, Pandey A, Nampoothiri KM (2015) Characterization of an exopolysaccharide with potential health-benefit properties from a probiotic Lactobacillus plantarum RJF 4. LWT Food Sci Technol 64(2):1179–1186. https://doi.org/10.1016/j.lwt.2015.07.040
Halliwell B, Chirico S (1993) Lipid peroxidation: its mechanism, measurement, and significance. Am J Clin Nutr 57(5 Suppl):715S–725S. https://doi.org/10.1093/ajcn/57.5.715S
Wang AN, Yi XW, Yu HF, Dong B, Qiao SY (2009) Free radical scavenging activity of Lactobacillus fermentum in vitro and its antioxidative effect on growing-finishing pigs. J Appl Microbiol 107(4):1140–1148. https://doi.org/10.1111/j.1365-2672.2009.04294.x
Milardović S, Iveković D, Grabarić BS (2006) A novel amperometric method for antioxidant activity determination using DPPH free radical. Bioelectrochemistry 68(2):175–180. https://doi.org/10.1016/j.bioelechem.2005.06.005
Han Q, Kong B, Chen Q, Sun F, Zhang H (2017) In vitro comparison of probiotic properties of lactic acid bacteria isolated from Harbin dry sausages and selected probiotics. J Funct Foods 32:391–400. https://doi.org/10.1016/j.jff.2017.03.020
De Freitas JM, Meneghini R (2001) Iron and its sensitive balance in the cell. Mutat Res 475(1–2):153–159. https://doi.org/10.1016/S0027-5107(01)00066-5
Ahotupa, Saxelin, Korpela (1996) Antioxidative properties of Lactobacillus GG. Nutr Today 31(31):51S. https://doi.org/10.1097/00017285-199611001-00018
Makras L, Vuyst LD (2006) The in vitro inhibition of Gram-negative pathogenic bacteria by bifidobacteria is caused by the production of organic acids. Int Dairy J 16(9):1049–1057. https://doi.org/10.1016/j.idairyj.2005.09.006
Sanders JW, Leenhouts KJ, Haandrikman AJ, Venema G, Kok J (1995) Stress response in Lactococcus lactis: cloning, expression analysis, and mutation of the lactococcal superoxide dismutase gene. J Bacteriol 177(18):5254–5260. https://doi.org/10.1128/jb.177.18.5254-5260.1995
Achuthan AA, Duary RK, Madathil A, Panwar H, Kumar H, Batish VK, Grover S (2012) Antioxidative potential of lactobacilli isolated from the gut of Indian people. Mol Biol Rep 39(8):7887–7897. https://doi.org/10.1007/s11033-012-1633-9
Yang HS, Yu JC, Oh HH, Moon JS, Jung HK, Kim KJ, Choi BS, Lee JW, Chang KH (2014) Antioxidative activity of mushroom water extracts fermented by lactic acid Bacteria. J Korean Soc Food Sci Nutr 43(1):80–85. https://doi.org/10.3746/jkfn.2014.43.1.080
Lee J, Hwang KT, Chung MY, Cho DH, Park CS (2010) Resistance of Lactobacillus casei KCTC 3260 to reactive oxygen species (ROS): role for a metal ion chelating effect. J Food Sci 70(8):m388–m391. https://doi.org/10.1111/j.1365-2621.2005.tb11524.x
García-Cayuela T, Korany AM, Bustos I, Cadiñanos LPGD, Requena T, Peláez C, Martínez-Cuesta MC (2014) Adhesion abilities of dairy Lactobacillus plantarum strains showing an aggregation phenotype. Food Res Int 57(1):44–50. https://doi.org/10.1016/j.foodres.2014.01.010
Salyers AA, Gupta A, Wang Y (2004) Human intestinal bacteria as reservoirs for antibiotic resistance genes. Trends Microbiol 12(9):412–416. https://doi.org/10.1016/j.tim.2004.07.004
Ammor MS, Flórez AB, Mayo B (2007) Antibiotic resistance in non-enterococcal lactic acid bacteria and bifidobacteria. Food Microbiol 24(6):559–570. https://doi.org/10.1016/j.fm.2006.11.001
Ramiah K, Doeschate KT, Smith R, Dicks LMT (2009) Safety assessment of Lactobacillus plantarum 423 and Enterococcus mundtii ST4SA determined in trials with Wistar rats. Probiotics Antimicrob Proteins 1(1):15–23. https://doi.org/10.1007/s12602-009-9010-2
Funding
This study was supported by the Chinese Natural Sciences Foundation (31672532, 31101845) and the Natural Science Foundation of Heilongjiang Province (Grant No. LC2015006).
Author information
Authors and Affiliations
Corresponding author
Ethics declarations
Ethical Approval/Ethics Statement
The experimental protocol (20119) was accepted by the international recommendations for animal welfare and the Ethical Committee for animal sciences of Heilongjiang Province.
Conflict of Interest
None of the authors of this paper has a financial or personal relationship with other people or organizations that could inappropriately influence or bias the content of the paper.
Rights and permissions
About this article
Cite this article
Shi, Y., Cui, X., Gu, S. et al. Antioxidative and Probiotic Activities of Lactic Acid Bacteria Isolated from Traditional Artisanal Milk Cheese from Northeast China. Probiotics & Antimicro. Prot. 11, 1086–1099 (2019). https://doi.org/10.1007/s12602-018-9452-5
Published:
Issue Date:
DOI: https://doi.org/10.1007/s12602-018-9452-5